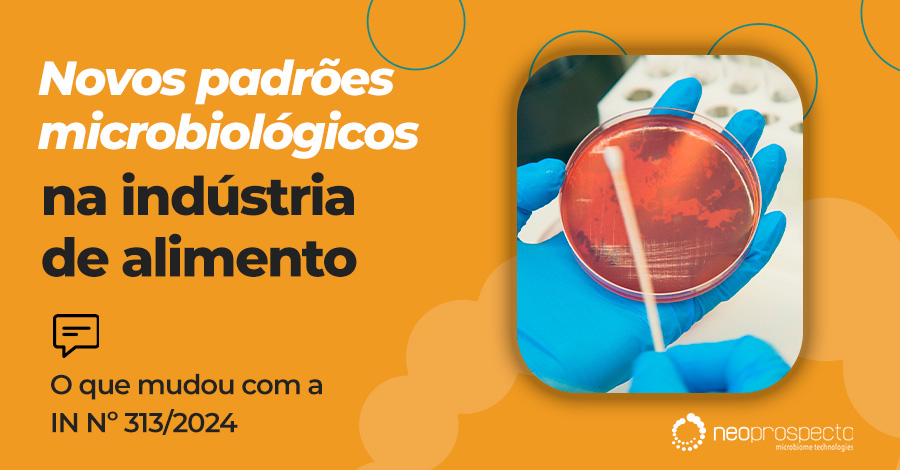
Controle de Qualidade, Food Safety, Indústria Alimentícia

A qualidade e a segurança microbiológica dos alimentos constituem aspectos fundamentais para a indústria de alimentos e, em última análise, para a saúde pública. A Instrução Normativa nº 313, de 4 de setembro de 2024, recentemente publicada pelo Ministério da Saúde/Agência Nacional de Vigilância Sanitária (ANVISA), trouxe importantes atualizações acerca dos padrões microbiológicos de alimentos, revogando a Instrução Normativa nº 161 de 1º de julho de 2022, INSTRUÇÃO NORMATIVA Nº 313, DE 4 DE SETEMBRO DE 2024, pag. 1. Este artigo se propõe a discutir essas atualizações em detalhes, enfatizando suas implicações para a indústria de alimentos, em especial para os profissionais do controle de qualidade.
O que são padrões microbiológicos?
Padrões microbiológicos são critérios definidos para assegurar a inocuidade dos alimentos comercializados. Eles estabelecem limites necessários para a presença de micro-organismos em várias categorias de alimentos, com a finalidade de prevenir doenças veiculadas por alimentos e de assegurar a qualidade dos produtos.
Instrução normativa Nº 161/2022: Um breve resumo
A Instrução Normativa N.º 161/2022 foi o fundamento para instituir os padrões microbiológicos para alimentos no Brasil. Ela fixou uma lista de microrganismos e toxinas a serem controlados dentro de várias categorias alimentares, abrangendo carnes, laticínios, pescados ou produtos vegetais, entre outros. O documento contemplava definições relevantes, como alimentos comercialmente estéreis, alimentos prontos para o consumo, alimentos semielaborados e outras categorias IN_161_2022, páginas 1-4
Principais alterações da instrução normativa Nº 313/2024
A nova Instrução Normativa Nº 313/2024 trouxe atualizações significativas para a IN 161/2022, que afetam diretamente os padrões microbiológicos de alimentos. As principais alterações são as seguintes:
1. Isenção de padrões microbiológicos para certos alimentos
- Aeróbios mesófilos: Os padrões microbiológicos para aeróbios mesófilos não se aplicam a alimentos que realizam processos com a adição de tais micro-organismos, os quais interferem na contagem deles. Esta isenção aplica-se também aqueles que são considerados ingredientes para outros alimentos que passaram por essa adição de micro-organismos.
- Bolores e leveduras: Idem para os padrões microbiológicos para bolores e leveduras, os quais não se aplicam aos alimentos que contêm os micro-organismos nos processos de sua obtenção INSTRUÇÃO NORMATIVA Nº 313, DE 4 DE SETEMBRO DE 2024, página 1.
2. Atualizações específicas nas categorias 5 e 6
As categorias 5 e 6 do Anexo I da Instrução Normativa 161/distrito de 18 de dezembro de 2008 foram revistas. Estas categorias referem-se a produtos cárneos, tais como carne de aves, carne bovina, suína e outros. As alterações especificadas afetam as especificações microbiológicas dos produtos e foram incorporadas no Anexo da nova Instrução Normativa.
- Categoria 5: Abrange carnes de aves, produtos cárneos crus à base de carne de aves e produtos cárneos semielaborados.
- Categoria 6: Refere-se à carne bovina, suína e outras carnes, incluindo produtos crus, moídos e produtos cárneos maturados ou processados INSTRUÇÃO NORMATIVA Nº 313, DE 4 DE SETEMBRO DE 2024, página 2.
3. Revogação de disposições anteriores
Além das alterações, a nova instrução normativa revogou o parágrafo único do artigo 7º e o Anexo IV da Instrução Normativa Nº 161/2022. O Anexo IV tratava do padrão microbiológico de Salmonella spp para alimentos de categorias específicas de carne suína IN_161_2022, página 6.
Impacto na indústria de alimentos
A atualização dos padrões microbiológicos tem impacto direto em diversos segmentos da indústria de alimentos, entre os quais:
- Indústria de carnes e produtos cárneos: Carnes de aves, bovinas e suínas, bem como produtos cárneos processados, tiveram alterações nos padrões, afetando diretamente os controles de qualidade e segurança desses produtos.
- Indústria de produtos lácteos: Os critérios para enterotoxinas estafilocócicas e outras bactérias continuam sendo relevantes, mas a IN 313 trouxe exceções para produtos com processos de adição de micro-organismos viáveis.
- Produtos prontos para consumo: Alimentos que apresentam deterioração que altere características físicas, químicas ou organolépticas agora são considerados de qualidade inaceitável, não estando sujeitos a alguns dos padrões microbiológicos definidos.
Como o Sequenciamento de DNA auxilia na manutenção dos padrões microbiológicos
O sequenciamento de DNA é uma técnica avançada que permite à indústria de alimentos identificar e monitorar micro-organismos presentes em seus produtos e ambientes de produção de forma precisa e rápida. Essa tecnologia possibilita a identificação de possíveis contaminações, rastreando a origem dos micro-organismos e ajudando a identificar fontes potenciais de contaminação. Além disso, ela permite o monitoramento contínuo da higiene nas linhas de produção e valida os processos de higienização, garantindo que os padrões microbiológicos sejam atendidos de forma eficaz e segura.
O sequenciamento de DNA também é capaz de identificar micro-organismos que são difíceis de detectar por métodos tradicionais, oferecendo uma ferramenta poderosa para manter a segurança e qualidade dos alimentos. Ao implementar o sequenciamento de DNA, a indústria de alimentos pode garantir a conformidade com as normas regulatórias, reduzindo riscos e assegurando a produção de alimentos mais seguros e com qualidade controlada. Baixe o e-Book gratuito e aprofunde-se nesse tema: Baixar o eBook.
Conclusão
A Instrução Normativa Nº 313/2024 representa uma atualização importante nos padrões microbiológicos de alimentos, proporcionando maior clareza e ajustes necessários para os processos da indústria de alimentos. Profissionais de controle de qualidade devem revisar essas mudanças cuidadosamente para garantir a conformidade com os padrões revisados e adaptar seus processos de monitoramento microbiológico. Manter-se atualizado sobre essas instruções é fundamental para garantir a segurança e a qualidade dos alimentos que chegam ao consumidor final.
Para obter detalhes completos sobre as alterações, consulte a Instrução Normativa INSTRUÇÃO NORMATIVA Nº 313, DE 4 DE SETEMBRO DE 2024.